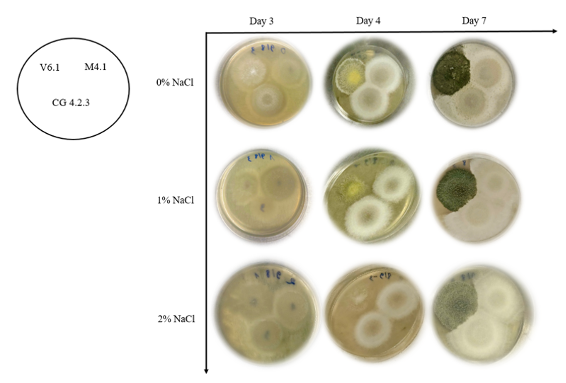
1-1774723765.png

Abstract
Salinity intrusion in the Mekong Delta is becoming increasingly complex, leading to severe soil degradation and reduced agricultural productivity. This study aims to select and synthesize a microbial product based on salt-tolerant Trichoderma fungi for the restoration of saline soils. Three fungal strains (T. asperellum M4.1, T. asperellum V6.1, and T. caribbaeum CG4.2.3) were studied for their growth in saline environments. The results showed that strain T. asperellum V6.1 exhibited the best salinity tolerance, both in terms of colony diameter and spore density. The preparation was produced using solid-state fermentation with an optimal substrate ratio of 3:1 (rice husk:rice bran). Laboratory tests on saline soil treatment showed that after 7 days, the addition of 15g of the preparation yielded significant results: electrical conductivity (EC) decreased from 2.14 to 1.87 mS/cm, soil pH changed from acidic (3.5) to an appropriate (5.5) level, and the content of essential nutrients (available phosphorus, total nitrogen, and organic carbon) increased. These results confirm the potential of T. asperellum V6.1 as a sustainable biological solution to replace costly traditional leaching methods, thereby contributing to soil improvement and the development of climate-smart agriculture.
Keyword: Trichoderma, saline soil, salt-tolerant.
JEL Classification: Q50, Q51, Q54, Q55.
1. INTRODUCTION
The Mekong Delta plays a vital agricultural role in Vietnam; however, the stability of this region is seriously threatened by climate change and upstream flow changes. Event such as rising sea levels, prolonged dry seasons, and changes in rainfall patterns, combined with the operation of upstream hydropower dams, have led to a sharp decrease in river flow during the dry season, making worse saltwater intrusion (Hong et al., 2019; Son et al., 2024). This saltwater intrusion not only decreases freshwater resources but also devastates agricultural land through salt accumulation, altering soil structure and inhibiting microbial activity.
Specifically, in alkaline-saline environments, Na+ displaces essential divalent ions such as calcium Ca2+ and magnesium Mg2+ at cation exchange sites, leading to the dispersion of clay particles (Mukhopadhyay et al., 2021).
Environmentally, high salt concentrations reduce freshwater habitats, causing biodiversity loss and severely impacting fish, crustaceans, and riparian vegetation. More seriously, prolonged salinization reduces groundwater levels, leading to the oxidation of sulfate-acid soils and the release of toxic ions such as Fe²⁺, Al³⁺, and SO₄²⁻ (Tran et al., 2021).
Millions of people in the Mekong Delta are facing shortages of drinking water and clean water for daily life and production, leading to health risks from using unsafe water sources. In agriculture, high salinity and the accumulation of Na⁺ in the soil directly harm plant roots, causing plant death and reducing the yield of essential crops such as rice and fruit trees (Tran et al., 2021).
Against this backdrop, biological methods are attracting significant attention. Numerous studies worldwide have demonstrated that microbial systems can reduce soil salinity through electrochemical and biological interactions, opening up a promising new direction for the restoration of saline soils (Han et al., 2021; Aber et al., 2023; Salehmin et al., 2021).
Among beneficial microorganisms, fungi of the genus Trichoderma stand out as promising candidates. According to meta-analyses, Trichoderma promotes salt tolerance through mechanisms that reduce soil Na+ content, stimulate root growth, and produce organic acids and enzymes that alter soil structure and chemical composition. Notably, Trichoderma possesses the gene encoding the enzyme ACC deaminase (ACCD). Under saline conditions, plants produce excessive amounts of ethylene, leading to inhibition of root development. The ACCD enzyme secreted by the fungus breaks down ACC (a precursor of ethylene) into α-ketobutyrate and ammonia, thus reducing the concentration of ethylene. This allows roots to maintain their growth rate and absorb water and nutrients in a hypertonic environment (Cheng et al., 2023). In particular, some strains, such as Trichoderma asperellum RM-28, are capable of surviving in saline environments, thus enhancing soil remediation efficiency (Anam et al., 2019). In Vietnam, although Trichoderma has been successfully studied and applied in plant disease control (Nguyen Tien Dung et al., 2022), its use for saline soil restoration remains limited.
Potential brands and products (research or application): Large agricultural biotechnology companies such as Novozymes (Denmark), Bayer (primarily Crop Science), BASF, and Syngenta all offer agricultural microbial preparations. Some may be researched or applied to salt-tolerant/stress-resistance crop.
2. RESEARCH METHODS
2.1. Time And place of research
Time and location of the research was carried out from February 10, 2025 to September 30, 2025 at the laboratory of the Faculty of Natural Resources and Environment, Polytechnic University - National University Ho Chi Minh City. Experiments were conducted on PDA medium, salt water medium and saline soil. The analytical parameters of all chemicals used in this study met analytical standards and were imported from certified suppliers. The study included conidia concentration, microbial growth rate, salinity, EC, pH, total nitrogen, and Olsen P measured and analyzed at the Laboratory of the Faculty of Natural Resources and Environment, Polytechnic University.
2.2. Material and chemical
Trichoderma asperellum M4.1, Trichoderma asperellum V6.1, Trichoderma caribbaeum CG4.2.3 were taken from the laboratory of the Faculty of Natural Resources and Environment, Ho Chi Minh City University of Technology, Vietnam. And Nitten GB (Nitten Liquid Fertilizer GB), 1,5% nitrogen, Potassium 3,5% from Nippon Beet Sugar Manufacturing Co.,Ltd.
All reagents and chemicals were provided by commercial suppliers and distilled water was used throughout the experiments chemiscal from China included Tween 80; Potassium dichromate; Sulfuric acid; Phosphoric acid; Ferric sulfate; Boric Acid; Tin(II) Chloride; Sodium thiosulfate; Amoni molybdat; Potassium sulfate; Copper Sulfate; Ferroin; And consumable for experiences
Incubator (24–35°C), orbital shaker (150rpm), autoclave, sterile culture cabinet, hemocytometer, conductivity meter (calibrated), violet vibrating paper, UV-Vis spectrophotometer, balance, drying oven, sieve.
2.3. Research method
Evaluation salt tolerance of three Trichoderma spp: The PDA solutions were autoclaved at 125°C for 1.5 hours after the sterilization process, incubated for 24 hours before fungal inoculation.
Three conidia ( T. asperellum M4.1, T. asperellum V6.1, and T. caribbaeum CG4.2.3) into new PDA plate with various concentrations of NaCl (0%, 1% and 2%), then continue incubate at room temperature for 7 days (meansured three times, day 3, 4 and 7).
For conidia harvesting, preparing a 0.1% Tween 80 solution and add 5ml of the solution to each Petri dish using a sterile micropipette. The microbial concentration is measured using a hemocytometer.
Two substrates were selected: rice husk and rice bran, dried at 100–120°C for 1-2 hours and mixed according to the experimental ratios specified in Table 3.
Table 2.3: Substrate formulas
|
Treatment |
Ratio of rice husk: rice bran |
Total dry substrate weight |
Rice husk weight |
Rice bran weight |
|
1 |
3:1 |
200 |
150 |
50 |
|
2 |
2:1 |
200 |
133 |
67 |
|
3 |
1:1 |
200 |
100 |
100 |
|
4 |
1:2 |
200 |
67 |
133 |
Evaluating the ability to desalinate saline soil and comparing microbial product form Trichoderma with other desalination products after three days.
Saline soil samples were collected from agricultural areas in Long An province, Mekong Delta, adjusted to approximately 20-30% throughout the incubation period (7 days).
2.4. Calculation of soil parameter
Determination of microbial concentration
The microbial concentration is determined by the hemocytometer method1. Each microbial strain is counted 3 times (0.1µl/time)2. The microbial concentration (cells/ml) is calculated using the formula:
Determination of pH and temperature
Soil pH was determined in a soil-water suspension at a ratio of 1:5 (w/v), following the TCVN 5979:2007 standard. EC of soil according to method TCVN 6650:2000. Total N concentration in soil was determined by Kjendahl method according to TCVN 6638:2000. The concentration of P2O5 in soil was determined by spectrophotometric absorption measurement according to TCVN 5256:2009. Organic carbon concentration in soil is determined by the Walkley - Black method according to TCVN 9294:2012. Data were analyzed by using one-way analysis of variance (ANOVA) to determine significant differences between treatments. Means were compared using Tukey's HSD (true significance) test at a significance level of p < 0.05. All statistical analyses were performed using SPSS software. Values are presented as mean ± standard deviation (SD).
3. RESULTS AND DISCUSSION
3.1. Growth results of Trichoderma strains
In all three treatments, it was shown that Trichoderma asperellum V6.1 strain grew strongly and the growth of Trichoderma asperellum M4.1 and Trichoderma caribbaeum CG4.2.3 strains gradually weakened as the salt concentration increased (Table 3.1)
Table 3.1: The growth of three Trichoderma strains (cm) at three NaCl concentrations: 0%, 1%, and 2%.
|
NaCl concantration |
Trichoderma strains |
Day 3 |
Day 4 |
Day 7 |
|
0% |
T. asperellum V6.1 |
4.33 ± 0.04a |
4.43 ± 0.09a |
4.66 ± 0.09a |
|
T. asperellum M4.1 |
3.79 ± 0.04b |
3.81 ± 0.09b |
3.97 ± 0.05b |
|
|
T. caribbaeum CG4.2.3 |
3.38 ± 0.10cd |
3.36 ± 0.05d |
3.46 ± 0.04de |
|
|
1% |
T. asperellum V6.1 |
3.49 ± 0.03c |
3.63 ± 0.09c |
3.76 ± 0.09c |
|
T. asperellum M4.1 |
2.94 ± 0.07f |
3.12 ± 0.02ef |
3.36 ± 0.05def |
|
|
T. caribbaeum CG4.2.3 |
2.80 ± 0.05gh |
2.98 ± 0.07gh |
3.19 ± 0.04gh |
|
|
2% |
T. asperellum V6.1 |
3.12 ± 0.07e |
3.22 ± 0.04e |
3.46 ± 0.03d |
|
T. asperellum M4.1 |
2.82 ± 0.08fg |
3.03 ± 0.03fg |
3.23 ± 0.07g |
|
|
T. caribbaeum CG4.2.3 |
2.48 ± 0.11i |
2.71 ± 0.03i |
2.86 ± 0.07i |
Salt tolerance in Trichoderma is directly regulated by the expression of genes involved in homeostasis and detoxification. As salt concentrations increase, the Trichoderma genome activates genes encoding ion-transporting proteins, particularly those belonging to the major transporter superfamily (MFS), play a crucial role in actively ejecting Na+ ions from the cell or isolating them in vacuoles. Simultaneously, to counteract oxidative stress caused by salt, the fungal genome stimulates the expression of genes encoding endogenous antioxidant enzyme systems, such as superoxide dismutase (SOD), catalase (CAT), and peroxidase (POD).
Results from Table 3.1 show that the higher the salt concentration, the slower the vegetative growth rate in all three strains. Strain T. asperellum V6.1 showed lead over the other two strains. At the highest salt concentration (2%), the colony diameter of V6.1 still reached 3.46 cm on day 7, only slightly reduced compared to the salt-free environment (4.66 cm). This indicates that the mycelium of V6.1 has good adaptability and maintains its tension (osmotic pressure) in a saline environment. Strain T. asperellum M4.1: Showed moderate tolerance, reaching 3.23 cm at a concentration of 2%. Strain T. caribbeum CG4.2.3 was the most sensitive strain to salt when at a concentration of 2%, the diameter only reached 2.86 cm.
Through figure 4.1, in general, three NaCl concentrations, strain V6.1 always shows better growth than the other two strains, although there is still a slight decrease in growth ability when grown in environments with high salt concentrations. In the early stages (Day 3), colonies mainly appear as cottony white mycelia, spreading from the initial inoculation points on the surface of the agar plate. As time progresses to days 4 and 7, the change in color becomes evident.
Table 3.2 further reinforces the fact that NaCl concentration is inversely proportional to the concentration of microbial growth. Nevertheless, strain V6.1 still shows good salt tolerance, as it can maintain a conidia density of 106 CFU/ml even at a salt concentration of 2% (1.12 × 106 CFU/ml), nearly equivalent to the density at 1% (1.11 × 106 CFU/ml). This ability to maintain a stable population is a key factor ensuring effectiveness when applied to actual saline soils.
Table 3.2: The microbial concentrations of three Trichoderma strains obtained after 7 days at three NaCl concentrations of 0%, 1%, and 2%.
|
Salt concentration |
0% |
1% |
2% |
|
T. asperellum M4.1 |
5.20 ± 0.11 x 105 |
3.47 ± 0.18 x 105 |
3.33 ± 0.17 x 105 |
|
T. asperellum V6.1 |
1.65 ± 0.05 x 106 |
1.11 ± 0.07 x 106 |
1.12 ± 0.04 x 106 |
|
T.caribbaeum CG4.2.3 |
9.73 ± 0.75 x 105 |
3.47 ± 0.14 x 105 |
1.33 ± 0.04 x 105 |
On the other hand, strain M4.1, it also can maintain a conidia concentration at a salt concentration of 2% (3.33 × 105 CFU/ml), almost similar to the density at 1% (3.47 × 105 CFU/ml). Meanwhile, strain CG4.2.3 experienced a significant decrease in density, from 9.73 × 105 (0%) to 1.33 × 105 CFU/ml (2%).
3.2. Results of substrate mixing treatments
Table 3.3: The concentration of conidia of four substrate mixture treatment
|
Experiment treatment |
Concentration of conidia (CFU/g) |
![]() Figure 3.2: The growth of fungal in four experiment treatment after 10 days |
|
3 : 1 |
2,30 ± 0,20×105 a |
|
|
2 : 1 |
1,50 ± 0,30×105 b |
|
|
1 : 1 |
8,00 ± 1,00×104 c |
|
|
1 : 2 |
3,00 ± 2,00×104 d |
The experimental data clearly shows that the 3:1 substrate ratio (rice husk to rice bran) was the most effective of 4 experiment treatment for Trichoderma asperellum V6.1 growth, achieving the highest density of 2.3 x 105 CFU/g. This was significantly higher than the 2:1 ratio, which produced 1.5 x 105 CFU/g. The 1:1 mixture resulted in only 8.0 x104 CFU/g, while the 1:2 ratio performed the worst, reaching just 3.0 x 104 CFU/g.
Rice husk plays a crucial role as a structural agent, providing porosity to ensure sufficient oxygen supply for the aerobic respiration of Trichoderma fungi. While rice bran provides essential nutrients such as starch and protein, an excessive amount (observed at ratios of 1:1 and 1:2) tends to make the substrate dense and sticky. This density restricts air circulation and can lead to overheating due to metabolic activity, thus inhibiting fungal growth and spore formation. Therefore, a 3:1 ratio provides an optimal balance between aeration and nutrients.
3.3. Evaluating the desalination capacity of experiment treatment to NaCl solution
At all salt concentrations (0%, 1%, 2%), while the blank treatment showed the same EC during the experiment, all treatments showed an increase in EC on day 4 because during this period Trichoderma fungi were very active in decomposing organic substrates (rice husks, rice bran). This mineralization process released nutrient ions (
Table 3.4: The change of electrical conductivity in water after using four microbial products
|
Treatments |
Day 0 |
Day 4 |
Day 7 |
|
Blank |
0.05 ± 0.01 |
0.05 ± 0.01e |
0.05 ± 0.01e |
|
3 : 1 |
0.05 ± 0.01 |
3.54 ± 0.11a |
3.26 ± 0.10a |
|
2 : 1 |
0.05± 0.01 |
2.76 ± 0.06b |
2.58 ± 0.12b |
|
1 : 1 |
0.05 ± 0.01 |
1.99 ± 0.03c |
1.82 ± 0.07c |
|
1 : 2 |
0.05 ± 0.01 |
1.52 ± 0.01d |
1.37 ± 0.03d |
In the water environment, the experiment ratio 3:1 showed the highest EC value among the four treatments, indicating the stronger mineralization compared to the other experiment treatment. Follow up with the ratio 2:1 treatment also showed the decreasing of EC between day 4 and day 7, but the amount of EC decrease was not higher than the experiment ratio 3:1. The third one was the ratio 1:1 treatment and the last was experiment ratio 1:2, these two showed the increase of EC in day 4 lower then the other two and also a slight decrease at day 7.
Table 3.5: The change of electrical conductivity in NaCl solution at a concentration 1% after using four microbial products
|
Treatments |
Day 0 |
Day 4 |
Day 7 |
|
Blank |
19.47 ± 0.08 |
19.47 ± 0.08 |
19.47 ± 0.08d |
|
3:1 |
19.47 ± 0.08 |
21.65 ± 0.44 |
20.35 ± 0.41c |
|
2:1 |
19.47 ± 0.08 |
21.62 ± 0.29 |
20.88 ± 0.65bc |
|
1:1 |
19.47 ± 0.08 |
21.92 ± 0.22 |
21.98 ± 0.56a |
|
1:2 |
19.47 ± 0.08 |
22.67 ± 0.14 |
21.92 ± 0.33ab |
In the 1% NaCl environment, this concentration is crucial for evaluating treatment capacity. Ratio 3:1: showed great recovery. By day 7, EC had decreased to 20.35 mS/cm quite similar with the initial level (19.47 mS/cm). Other ratios (2:1, 1:1, 1:2) showed a upward trend after day 4, the final EC remained higher than the initial level. This indicates that the salt treatment capacity of the fungus at these ratios was not strong enough to compensate for the amount of ions produced from substrate decomposition.
Table 3.6: The change of electrical conductivity in NaCl solution at a concentration 2% after using four microbial products
|
Treatments |
Day 0 |
Day 4 |
Day 7 |
|
Blank |
35.4 ± 0.22 |
35.4 ± 0.22c |
35.4 ± 0.22b |
|
3:1 |
35.4 ± 0.22 |
37.76 ± 0.76b |
35.44 ± 0.72b |
|
2:1 |
35.4 ± 0.22 |
37.68 ± 0.51b |
36.79 ± 1.14ab |
|
1:1 |
35.4 ± 0.22 |
38.37 ± 0.38ab |
38.31 ± 0.97a |
|
1:2 |
35.4 ± 0.22 |
39.29 ± 0.25a |
38.31 ± 0.57a |
In a 2% NaCl environment (input EC ~35.4 mS/cm), osmotic pressure became a major inhibitory factor. The 3:1 ratio was the only treatment that brought EC back to its initial level on day 7. This confirms that when cultured on an optimal substrate (abundant rice husks for aeration), T. asperellum V6.1 was still growth and maintains biological activity even under harsh conditions. While the ratio 2:1 treatment demonstrated the decrease between day 4 and day 7 but it still higher than the initial level. Evaluating the ability to desalinate saline soil and comparing microbial product form Trichoderma with other desalination products.
3.3.1. Changes in electrical conductivity (EC)
Table 3.7: EC of soil for each treatment on days 4 and 7
|
Treatment |
EC (mS/cm) day 0 |
EC (mS/cm) day 3 |
EC (mS/cm) day 7 |
|
Blank |
1.85 ± 0.03 |
1.92 ± 0.05b |
2.14 ± 0.06a |
|
Nitten GB |
1.85 ±0.04 |
2.28 ± 0.10a |
2.09 ± 0.08a |
|
Product 5g |
1.85 ± 0.02 |
2.10 ± 0.08ab |
1.94 ± 0.05b |
|
Product 10g |
1.85 ± 0.03 |
2.36 ± 0.12a |
1.90 ± 0.04bc |
|
Product 15g |
1.85 ± 0.02 |
2.41 ± 0.09a |
1.87 ± 0.03c |
In the untreated soil sample, EC tended to increase gradually over time, rising from an initial value of 1.85 ± 0.03 mS/cm to 2.14 ± 0.06 mS/cm by day 7. This happening reflects the natural state of saline soil as it dries the evaporation of water leads to an increased salt concentration in the soil solution. This confirms that, without intervention, the soil will continue to degrade and become more saline.
In all treatments using the prepared product (5g, 10g, 15g) and Nitten GB, a significant increase in EC was observed. This increase was not due to higher soil salinity, but rather to accelerated mineralization.
With a final conductivity of 1.87 ± 0.03 mS/cm quite similar with the initial EC, the treatment using 15g product showed the best salinity reduction effect compared with the blank (2.14 mS/cm). This conductivity level is within the safe range for many sensitive crops. Follow up with the treatment using 5g and 10g product also showed the decrease of EC between day 4 and day 7 but its still higher than the initial EC while the treatment used nitten GB was just slightly decrease during the same time. Therefore, the 15g product shown the best biological desalination ability among the experiment treatments.
The ability of Trichoderma strains to reduce soil EC is not due to direct chemical desalination reactions, but primarily relies on mechanisms that improve the soil's physical structure and biological ion binding capacity. As they spread and decompose organic matter, Trichoderma secretes polysaccharides and glycoproteins that act as binders, assembling loose soil particles into stable masses (Cheng et al., 2023; Rawat et al., 2016). This process increases soil porosity and significantly improves water conductivity, allowing water to dissolve and wash away excess salt ions (Na⁺, Cl⁻) from the root zone to deeper layers. Simultaneously, fungal humification produces humic compounds capable of adsorbing and complexing with mineral ions. This reduces the concentration of free ions in the soil solution, thus effectively decreasing EC value (Zhai et al., 2025).
3.3.2. Changes in concentration of pH
Table 3.8: pH Value of soil for each treatment
|
Treatment |
pH at day 0 |
pH at day 4 |
pH at day 7 |
Treatment |
pH at day 0 |
pH at day 4 |
pH at day 7 |
|
Blank |
4 |
4 |
3.5 |
|
|
|
|
|
Nitten GB |
4 |
4.5 |
5.5 |
Product 10g |
4 |
4.5 |
5.5 |
|
Product 5g |
4 |
4 |
5.0 |
Product 15g |
4 |
4.5 |
5.5 |
This preparation showed good efficacy in treating sulfated acidic soils by adjusting their pH. While all the treatment showed the increase of pH at day 7 at 5 and 5.5, the blank sample continued to show a pH decrease to 3.5 - a threshold that kills most beneficial microorganisms and young plant roots, reflecting the continuous oxidation of sulfated soil.
Firstly, the treatments with Trichoderma and Nitten GB prevented acidification while the experiment treatment T. asperellum V6.1 product at a weight of 10g, 15 g and Nitten GB solution showed a rapid increase in pH to 5.5 by day 7. This is the ideal pH for acid sulfate soils, where Al³⁺ begins to precipitate and lose its toxicity, and mineral nutrients become more readily available.
The 5g product only raised the pH to 5.0 but it still higher than the control (3.5), it was still below the optimal level, indicating that lower product's weight require a longer time to achieve the desired pH.
The product T. asperellum V6.1 (especially at 10 g or higher) acts as a biological buffer, not only preventing acidification, but also actively raising the soil pH to a level suitable for agricultural.
The effectiveness of Trichoderma fungal preparations for improving soil pH does not rely on direct chemical neutralization reactions like lime, but rather on indirect biological mechanisms related to matter metabolism. More specifically, when Trichoderma decomposes soil organic matter, it promotes humification and creates humic compounds (Zhai et al., 2025). These compounds are natural buffers with a high cation exchange capacity (CEC), which help regulate and stabilize the concentration of H+ ions in the soil solution. Furthermore, and this is crucial, in acidic environments, Trichoderma strains secrete specific organic compounds and siderophores with a high affinity for metals, chelating aluminum (Al3+)and iron (Fe2+) ions (Li et al., 2015; Nagoba & Vedpathak, 2011). This process prevents the hydrolysis reaction of metal ions that produces acid, thereby reducing potential acidity and raising the soil pH to a safe level for plant root growth (Pelagio-Flores et al., 2017).
3.3.3. Changes in concentration of olsen phosphorous content
Table 3.9: Olsen Phosphorous of soil for each treatment
|
Treatment |
Olsen P (mg/kg) |
Treatment |
Olsen P (mg/kg) |
|
Blank |
46.21 ± 3.0c |
Product 5g (3:1) |
64.83 ± 6.5b |
|
Blank after 7 days |
44.9 ± 2.2c |
Product 10g (3:1) |
84.87 ± 3.1a |
|
Nitten GB |
88.23 ± 3.9a |
Product 15g (3:1) |
86.74 ± 6.5a |
Overview, all of the experiment treatment showed the increasing of Olsen Phosphorous. While the one in the blank sample decreased from 47.66 mg/kg to 44.57 mg/kg after 7 days. This decrease is consistent with the decrease in pH, as when pH drops to 3.5, the soil's phosphorus fixation capacity reaches its maximum, depleting readily available phosphorus.
The treatments included Nitten GB, Product 15g, and Product 10g. The differences between these three treatments were not significant. This increase in readily olsen phosphorus is caused by the fungus, while the soil pH rise to 5.5 also helped release a large amount of phosphorus retained by soil colloids
T. asperellum V6.1 is an effective alternative to chemical phosphorus analysis. Instead of adding phosphorus fertilizer to the soil (which is easily immobilized), this product allows people to utilize the phosphorus reserves already present in the soil, saving on fertilizer costs and protecting the environment.
In the case of Olsen phosphate, Trichoderma fungi increase the amount of available phosphate through the dissolution and mineralization of insoluble phosphorus compounds. This is achieved by secreting low molecular weight organic acids (such as gluconic, citric, and fumaric acids) into the soil, locally acidifying the root zone and complexing with metal cations (Ca2+, Fe3+, Al3+), thereby breaking the bonds of precipitated phosphate salts to release orthophosphate ions (H2PO4-) (Li et al., 2015; Pelagio-Flores et al., 2017). Simultaneously, Trichoderma synthesizes phosphatase and phytase enzymes, catalyzing the hydrolysis of complex organic phosphorus compounds (such as phytate in plants), converting them into inorganic phosphate forms that can be directly supplied to plants (Zhao et al., 2015) .
3.3.4. Changes in concentration of total nitrogen content
Table 3.10: Total Nitrogen of soil for each treatment
|
Treatment |
Nitrogen Total (mg/kg) |
Treatment |
Nitrogen Total (mg/kg) |
|
Blank |
1148 ± 8.7d |
5g Product |
1412 ± 11.5c |
|
Blank after 7 days |
1148 ± 20.8d |
10g Product |
1610 ± 24.3b |
|
Nitten GB |
1855 ± 20.7a |
15g Product |
1813 ± 13.7a |
At the end of the experiment, the four sample use micriobial product and Nitten GB showed the increase of nitrogen total also there was a slightly differrent between three experiment treatment use microbial product. At the same time, the blank sample maintained low and constant nitrogen levels (~1148 mg/kg) due to the lack of supplemental sources. In contrast, nitrogen content increased linearly with the dose of the supplement used.
The significant increase in nitrogen content in the experiment treatments (especially the 15g product reaching 1813 ± 13.7 mg/kg) was not simply due to the addition of substrate. This was the result of biological mineralization by Trichoderma asperellum V6.1. The initial organic nitrogen was unabsorbable by the plant, but the fungus's conversion into mineral forms (NH4+, NO3-), the plant could immediately absorb it to restore its foliage after salt burn.
The T. asperellum V6.1 preparation showed that instead of applying chemical nitrogen fertilizers (which are easily leached and evaporated), it can provide a sustainable source of organic nitrogen through mineralization, increasing the total nitrogen content in the soil by 1.6 times compared to the blank, reaching a level equivalent to commercial products, ensuring essential nutritional needs for plants under saline stress conditions.
The increase in overall soil nitrogen content caused by Trichoderma fungi is primarily due to vigorous biomineralization processes. These fungi secrete extracellular enzymes, including proteases and chitinases, which help break down nitrogen macromolecules (such as proteins from plant residues or chitin from insect exoskeletons) into simpler forms such as amino acids and ammonium (NH4+) (Benítez et al., 2004; Lopez-Llorca et al., 2008). Furthermore, Trichoderma limits nitrogen loss due to evaporation by temporarily assimilating nitrogen into its biomass (Harman et al., 2004). During the aging and decomposition of the fungal hyphae, this nitrogen is returned to the soil in an easily absorbable organic form, thus establishing a closed and sustainable nitrogen.
3.3.5. Changes in concentration of organic carbon content
Table 3.11: Organic Carbon of soil for each treatment
|
Treatment |
OC (%) |
Treatment |
OC (%) |
|
Blank |
1.44 ± 0.02d |
5g Product |
1.63 ± 0.02c |
|
Blank after 7 days |
1.41 ± 0.03d |
10g Product |
1.71 ± 0.02b |
|
Nitten GB |
1.79 ± 0.01a |
15g Product |
1.75 ± 0.01ab |
The organic matter (OC) content in the blank sample decreased slightly over time (from 1.44% to 1.41%). This is a natural phenomenon of organic matter "burning": in tropical conditions, organic matter is oxidized and evaporates as CO2 without a compensatory source. Soils poor in organic matter will lead to a loose structure, poor water retention, and easy compaction – factors that exacerbate the harmful effects of salinity. While all the experiment treatment demonstrated the increasing of OC after 7 days.
The addition of the microbial product increased the OC providing more than just nutrient supply while the Trichoderma combined with organic matter from the rice husk forms materials that bind the clay particles together, creating a porous structure that facilitates desalination and enhances oxygen for root respiration.
The OC increase effect of Product 15g (1.75%) is statistically comparable to Nitten GB (1.79%). This confirms that a substrate mixing ratio of 3 parts rice husk to 1 part bran is the optimal formula for both conidia cultivation and leaving a useful amount of humus for the soil. Follow up with the experiment treatment of using 10g product while it showed the increasing quite similar to the other one using 15g product. Finally, the treatment used 5g product was the lowest at 4 experiment treatment.
The mechanism of organic carbon accumulation in soil by Trichoderma fungi is a result of humification combined with an increase in plant biomass (Li et al., 2015). As an effective cellulose-decomposing agent, Trichoderma does not convert straw and plant residues into volatile CO₂, but rather into precursors for the synthesis of stable humic and fulvic compounds – forms of carbon that are stored long-term in the soil structure (Zhai et al., 2025).
Comparative analysis between the product formulated based on Trichoderma and the commercial reference product (Nitten GB) demonstrated that the synthetic product has equivalent ability to remediate soil contaminated by saline solutions and improve nutrient availability. Specifically, soils treated with the product formulated at amount of 10g and 15g showed significant improvements in olsen phosphorous and total nitrogen, with values close to those achieved by commercial Nitten GB.
Regarding application treatment, the recommended optimal usage rate is a 10g treatment. Although the 15g experiment treatment showed slightly higher absolute values for some parameters, the statistical difference between the 10g and 15g treatments was not significant and did not justify an increase in material intake. Therefore, the 10g dose represents the most effective threshold, balancing agronomic efficiency and economic feasibility. It ensures sufficient microbial activity to minimize salinity and release nutrients without loss of effectiveness at concentrations higher than 15g.
4. Conclusion
Among the tested strains, Trichoderma asperellum V6.1 showed better salt tolerance. It maintains good vegetative growth and high conidia density even at 2% NaCl concentration, making it the most suitable candidate for microbial product formulation in saline soils.
The biological product was successfully prepared from T. asperellum V6.1. at a ratio of 3:1 (husk: rice bran) achieving spore density and survival ability, ensuring the highest activity potential in 4 experimental treatments.
At the same time, the treatment of 3 rice husks and 1 rice bran also showed the highest EC reduction ability among the 4 treatments.
The product significantly improved soil quality by reducing soil EC increasing pH, olsen phospherous content, total nitrogen and organic carbon. Notably, the nutrient improvement at the higher amount (10 g and 15 g) was comparable to the commercial reference product (Nitten GB).
Statistical analysis showed no significant difference in treatment efficiency (EC reduction and nutrient release) between the 10g and 15g treatments. Since the 15g product does not provide proportionally greater benefits, the 10g product represents the most economically and technically efficient ratio, maximizing performance while minimizing material costs.
To optimize salinity reduction and nutrient uptake, further research is needed on mixing these materials with other locally available organic substrates, such as biochar, well-rotted manure, or water hyacinth.
The current study demonstrates the effectiveness of the soil treatment after 7 days. However, the biological restoration process is generally slow and not sustainable. Extending the experiment duration (from 30 to 60 days or throughout a full growing season) allows Trichoderma sufficient time to establish a stable population and develop a mycelial network that penetrates deep into the soil structure.
Laboratory conditions (temperature, humidity, light) are strictly controlled and may differ from real-world conditions. It is crucial to conduct experiments directly in the saline areas of the Mekong Delta.
Furthermore, the experimentation must be expanded to assess the overall effectiveness of the product on target crops (e.g., salt-tolerant rice, fruit trees, or mangroves). Growth indicators (height, biomass, yield) and the plants' ability to absorb harmful substances must be measured.
Acknowledgement: The authors gratefully acknowledge the members of the Department of Environmental Engineering, Ho Chi Minh City University of Technology, for their valuable support during this study. In particular, the authors would like to thank Nguyễn Thị Thùy Dương and Nguyễn Thị Thủy Tiên from the Division of Microbial Biotechnology, Biotechnology Center of Ho Chi Minh City, for their assistance related to the microbial materials used in this work.
Le Thi Huynh Tram 1,2 , Trinh Thi Bich Huyen 1,2 , Le Nguyen Trong Nhan 1,2 , Nguyen Ngoc Van Anh 1,2, Dang Vu Bich Hanh 1,2*
1 Ho Chi Minh City University of Technology (HCMUT)
2 Vietnam National University Ho Chi Minh City
REFERENCES
1. Aber, S., Shi, Z., Xing, K., Rameezdeen, R., Chow, C. W., Hagare, D., & Jindal, T. (2023). Microbial desalination cell for sustainable water treatment: A critical review. Global Challenges, 7(10), 2300138. https://doi.org/10.1002/gch2.202300138
2. Anam, G. B., Reddy, M. S., & Ahn, Y. H. (2019). Characterization of Trichoderma asperellum RM-28 for its sodic/saline-alkali tolerance and plant growth promoting activities to alleviate toxicity of red mud. Science of the Total Environment, 662, 462–469. https://doi.org/10.1016/j.scitotenv.2019.01.017
3. Benítez, T., Rincón, A. M., Limón, M. C., & Codon, A. C. (2004). Biocontrol mechanisms of Trichoderma strains. International microbiology, 7(4), 249-260.
4. Cheng, L., Xu, Z., & Zhou, X. (2023). Application of Trichoderma species increases plant salinity resistance: A bibliometric and meta-analysis. Journal of Soils and Sediments, 23(7), 2641–2653. https://doi.org/10.1007/s11368-023-03406-8
5. Harman, G. E., Howell, C. R., Viterbo, A., Chet, I., & Lorito, M. (2004). Trichoderma species—opportunistic, avirulent plant symbionts. Nature Reviews Microbiology, 2(1), 43-56. https://doi.org/10.1038/nrmicro797
6. Han, X., Qu, Y., Li, D., Qiu, Y., Yu, Y., & Feng, Y. (2021). Remediation of saline-sodic soil by plant microbial desalination cell. Chemosphere, 277, 130275. https://doi.org/10.1016/j.chemosphere.2021.130275
7. Hồng, N. V., Thơ, P. T. A., & Lan, N. T. P. (2019). Biến đổi khí hậu và những tác động của biến đổi khí hậu đến phát triển bền vững tiểu vùng sinh thái ven biển Đồng bằng sông Cửu Long. Tạp chí Khí tượng Thủy văn, 707(8).
8. Li, R. X., Cai, F., Pang, G., Shen, Q. R., Li, R., & Chen, W. (2015). Solubilisation of phosphate and micronutrients by Trichoderma harzianum and its relationship with the promotion of tomato plant growth. PloS one, 10(6), e0130081. https://doi.org/10.1371/journal.pone.0130081
9. Lopez-Llorca, L. V., Maciá-Vicente, J. G., & Jansson, H. B. (2008). Mode of action and interactions of nematophagous fungi. In Integrated management and biocontrol of vegetable and grain crops nematodes (pp. 51-76). Dordrecht: Springer Netherlands.
10. Mukhopadhyay, R., Sarkar, B., Jat, H. S., Sharma, P. C., & Bolan, N. S. (2021). Soil salinity under climate change: Challenges for sustainable agriculture and food security. Journal of Environmental Management, 280, 111736. https://doi.org/10.1016/j.jenvman.2020.111736
11. Nagoba, B. S., & Vedpathak, S. J. (2011). Siderophores in Microbes. European Journal of General Medicine, 8(3), 229–235. https://doi.org/10.29333/ejgm/82728
12. Nguyễn, T. D., Nguyễn, T. T., Cao, T. T. D., Quách, T. H., Nguyễn, T. M. T., Phạm, K. P., Nguyễn, T. T. H., Phan, L. N., Trần, P. T., Trương, T. O., & Nguyễn, Đ. T. (2022). Nghiên cứu kỹ thuật sản xuất chế phẩm Trichoderma phòng trừ bệnh vàng lá – thối rễ trên cây có múi. VJST B, 64(9).
13. Pelagio-Flores, R., Esparza-Reynoso, S., Garnica-Vergara, A., López-Bucio, J., & Herrera-Estrella, A. (2017). Trichoderma-induced acidification is an early trigger for changes in Arabidopsis root growth and determines fungal phytostimulation. Frontiers in Plant Science, 8, 822. https://doi.org/10.3389/fpls.2017.00822
14. Rawat, L., Singh, Y., Shukla, N., & Kumar, J. (2016). Trichoderma: A native biological control agent for plant disease management and soil health. Biocontrol Science and Technology, 26(1), 1–21. https://doi.org/10.1080/09583157.2015.1074631
15. Rengel, Z. (2011). Soil pH, soil health and climate change. In Soil health and climate change (pp. 69-85). Berlin, Heidelberg: Springer Berlin Heidelberg. https://doi.org/10.1007/978-3-642-20256-8_4
16. Salehmin, M. N. I., Lim, S. S., Satar, I., & Daud, W. R. W. (2021). Pushing microbial desalination cells towards field application: Prevailing challenges, potential mitigation strategies, and future prospects. Science of the Total Environment, 759, 143485. https://doi.org/10.1016/j.scitotenv.2020.143485
17. Sơn, D. H., Linh, B. H., Đức, N. A., & Phương, T. A. (2024). Nghiên cứu đánh giá tác động kép của biến đổi khí hậu và các phát triển thượng nguồn đến xâm nhập mặn vùng Đồng bằng sông Cửu Long. Tạp chí Khí tượng Thủy văn, 763, 13–23. https://doi.org/10.36335/VNJHM.2024(763).13-23
18. Tran, D. D., Dang, M. M., Du Duong, B., Sea, W., & Vo, T. T. (2021). Livelihood vulnerability and adaptability of coastal communities to extreme drought and salinity intrusion in the Vietnamese Mekong Delta. International Journal of Disaster Risk Reduction, 57, 102183. https://doi.org/10.1016/j.ijdrr.2021.102183
19. USDA Salinity Laboratory Staff. (1954). Diagnosis and Improvement of Saline and Alkali Soils (USDA Handbook 60).
20. Zhai, S., Wang, K., Yu, F., Gao, Z., Yang, X., Cao, X., ... & Hamoud, Y. A. (2025). Effects of Trichoderma harzianum combined with Phanerochaete chrysosporium on lignin degradation and humification during chicken manure and rice husk composting. Frontiers in Microbiology, 16, 1515931. https://doi.org/10.3389/fmicb.2025.1515931
21. Zhao, L., Zhang, Y., Cui, Q.-Y., & Liang, Y.-C. (2015). Effects of phosphate solubilization and phytohormone production of Trichoderma asperellum Q1 on promoting cucumber growth under salt stress. Journal of Integrative Agriculture, 14(8), 1588–1597. https://doi.org/10.1016/S2095-3119(14)60966-7
